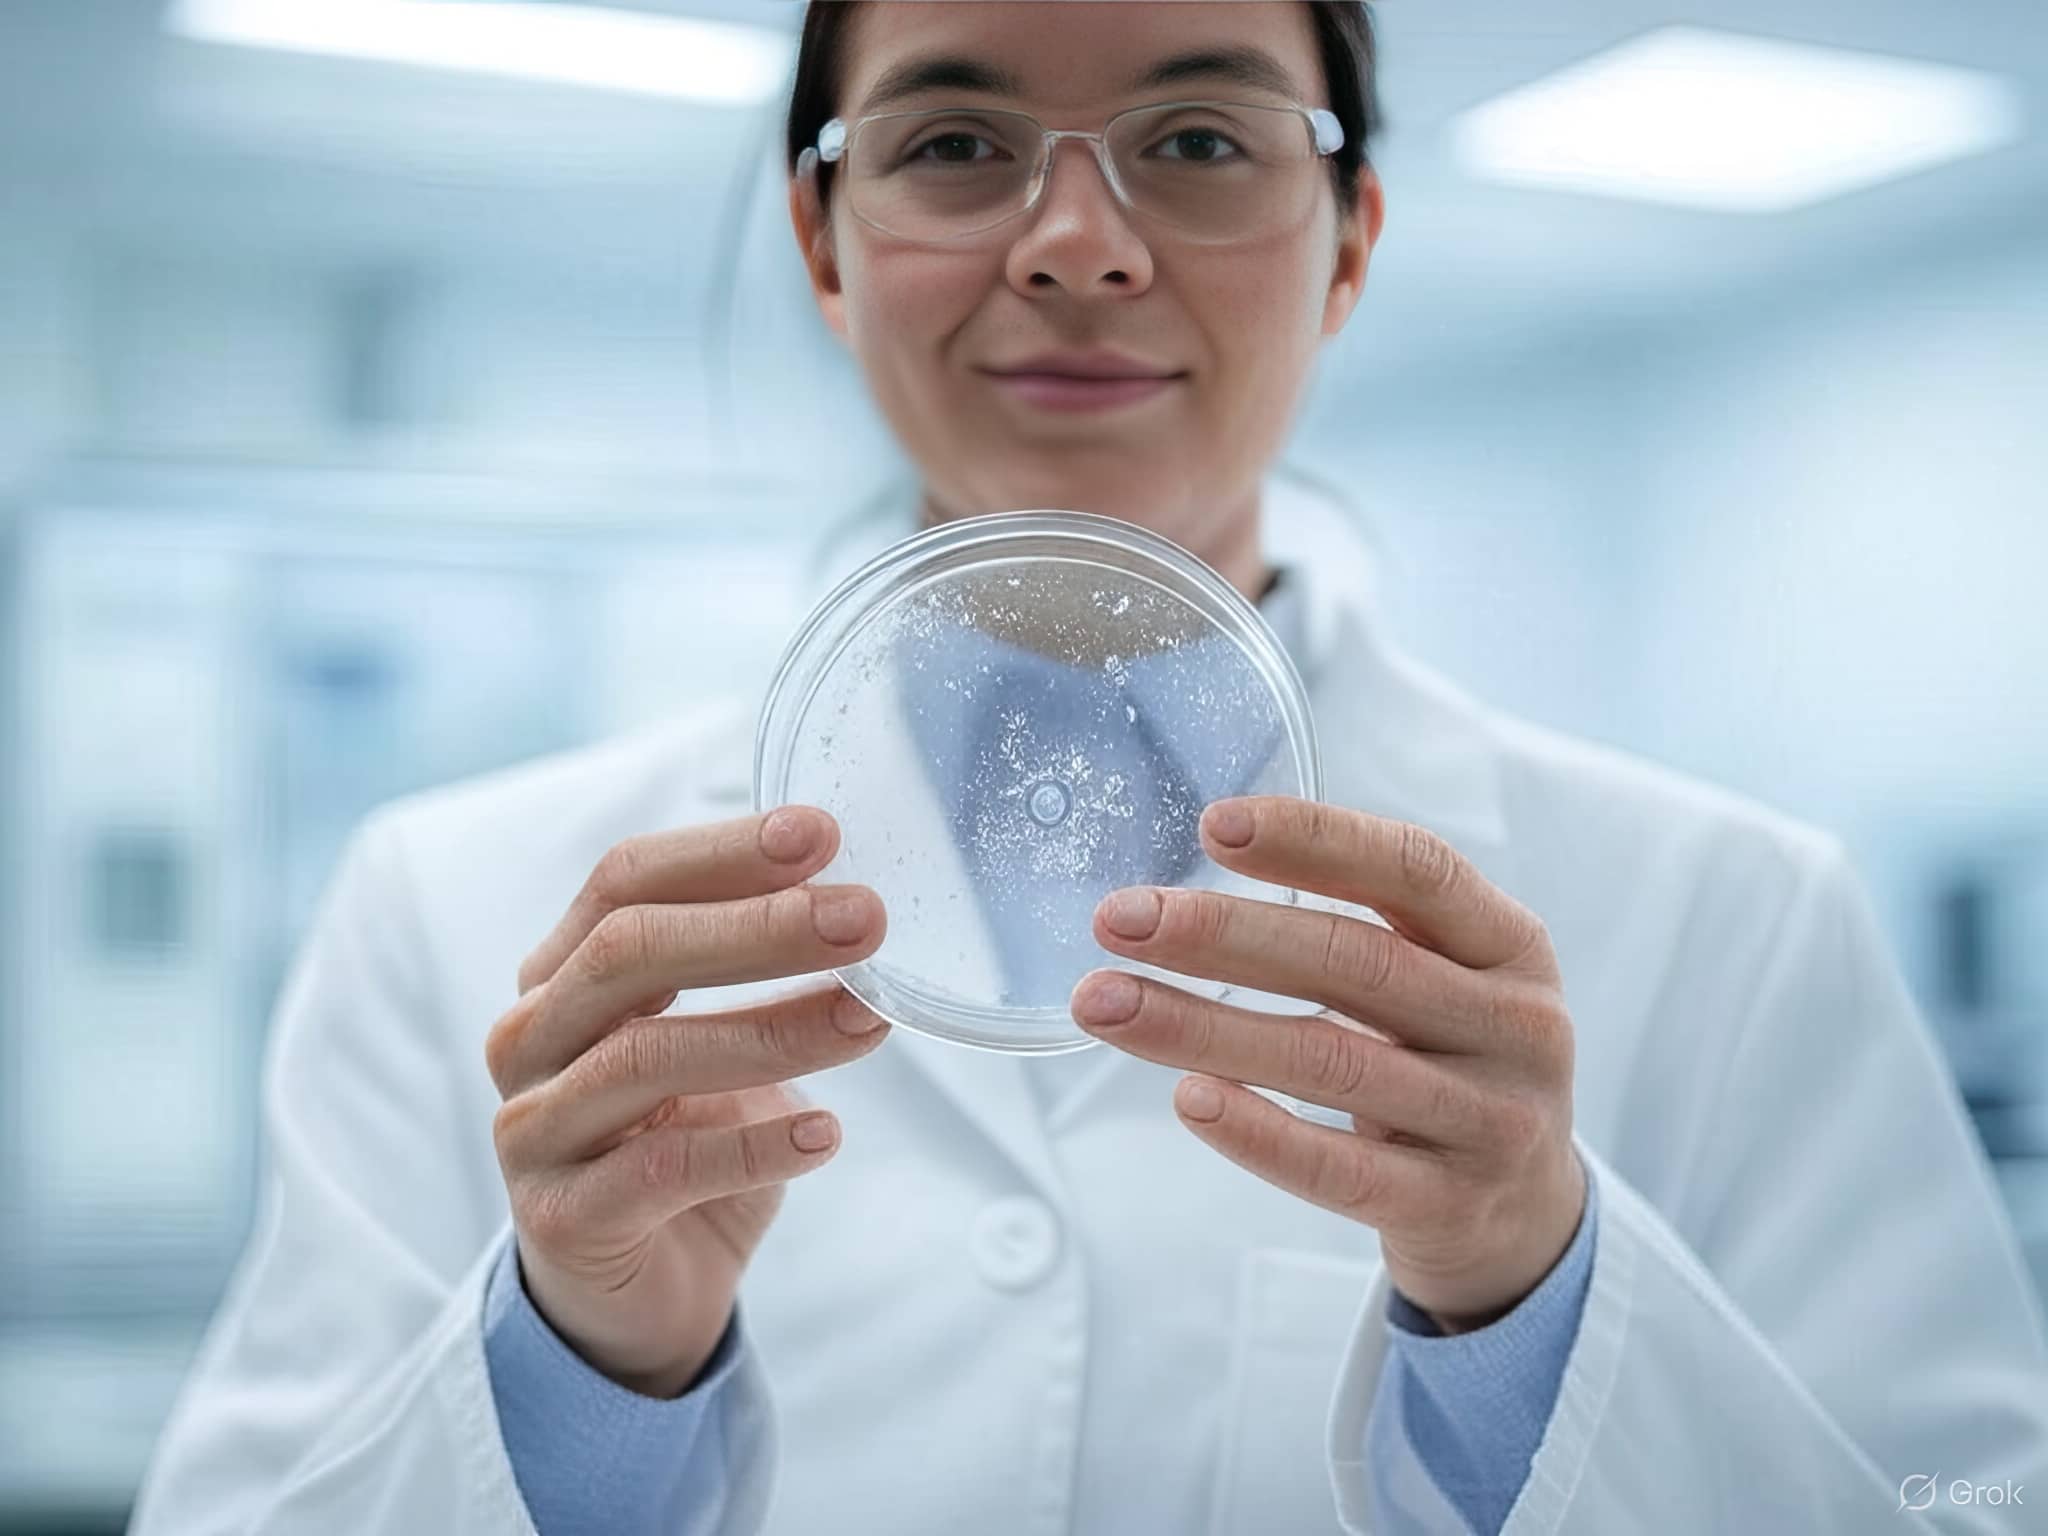
Tratamiento con Células Madre para el Autismo en Turquía

Parkinson’s affects millions, reducing their quality of life. With aging, cases increase, prompting an urgent search for solutions.

I’m sure you’ve heard of ALS, that disease that disrupts everything. Imagine lifting a cup or walking for

If you know Multiple Sclerosis (MS), you know how complicated it is. It’s a completely life-changing disease. It’s
If you have a child or family member with autism, you know what it’s like to face exhausting

Turkey is today one of the world’s most popular destinations for plastic surgery, and not by chance. Its
Visitandmedcare, where your health and well-being are our top priorities. We are dedicated to navigating the complexities of healthcare, ensuring accessible and exceptional treatment options for everyone, regardless of their background.
Visitandmedcare has over five years of experience in health tourism, known globally for its high service quality, welcoming visitors from all over the world. We specialize in connecting our patients from many different regions, particularly from Europe and the Middle East, with contracted hospitals and medical centers to provide accurate and reliable healthcare services.